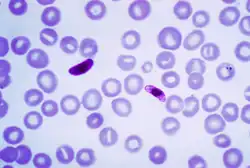

Plasmodium falciparum
Taxonavigation
| Taxonavigation: Haemospororida |
|---|
|
Superregnum: Eukaryota |
Familia: Plasmodiidae
Genus: Plasmodium
Species: Plasmodium falciparum
Name
Plasmodium falciparum (Welch, 1897)
Vernacular names
العربية: متصورة منجلية
català: Plasmodi falcípar
čeština: Zimnička tropická
नेपाली: प्लास्मोडियम फल्कीपारम
polski: Zarodziec sierpowy
中文: 恶性疟原虫
català: Plasmodi falcípar
čeština: Zimnička tropická
नेपाली: प्लास्मोडियम फल्कीपारम
polski: Zarodziec sierpowy
中文: 恶性疟原虫
This article is issued from Wikimedia. The text is licensed under Creative Commons - Attribution - Sharealike. Additional terms may apply for the media files.